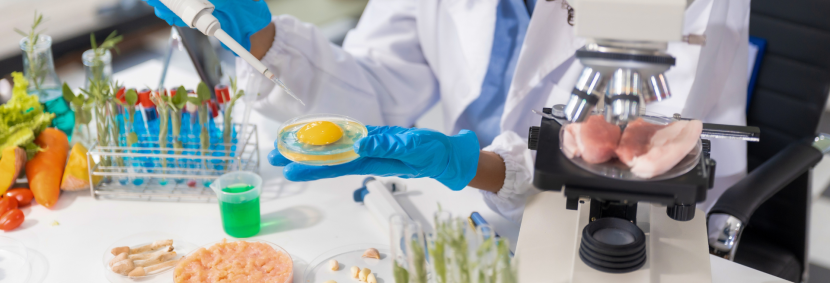

Curso de Nutrição da FCMSCSP: Formação Completa para o Profissional do Futuro
Se você busca uma carreira sólida e transformadora na área da saúde, o curso de Nutrição da Faculdade de Ciências Médicas da Santa Casa de São Paulo (FCMSCSP) é a escolha ideal. A Graduação da FCMSCSP forma nutricionistas generalistas, éticos e inovadores para atuar em diversos contextos de saúde e bem-estar.
Estrutura Acadêmica e Curricular
O curso de Nutrição da FCMSCSP segue as Diretrizes Curriculares Nacionais e oferece uma formação abrangente com 3220 horas de carga horária. Além disso, a matriz curricular inclui disciplinas teóricas e práticas, abordando temas como fisiologia, bioquímica, saúde coletiva, nutrição clínica, esportiva e hospitalar.
Dessa forma, os alunos participam de atividades práticas em um Serviço de Nutrição estabelecido em um hospital centenário, garantindo aprendizado de qualidade desde o início da formação.
Vivência Prática no Hospital da Santa Casa
Desde o início do curso, os alunos têm acesso à infraestrutura robusta da Irmandade da Santa Casa de Misericórdia, que favorece o desenvolvimento acadêmico e científico. Consequentemente, essa experiência prática contribui para a formação de profissionais humanizados e preparados para os desafios contemporâneos da Nutrição.
Parcerias e Reconhecimento Nacional
A FCMSCSP é reconhecida nacionalmente pela excelência na formação em saúde, figurando entre as melhores do país com nota máxima (5) no Índice Geral de Cursos Avaliados da Instituição (IGC) pelo MEC. Além disso, a faculdade mantém parcerias com serviços públicos e privados de excelência, bem como colaborações internacionais, ampliando oportunidades para os alunos.
Curso de Nutrição da FCMSCSP: Por que escolher?
Em primeiro lugar, formação humanizada: Desenvolve habilidades como ética, empatia e comunicação.
Além disso, infraestrutura de ponta: Laboratórios multidisciplinares e acesso ao Hospital da Santa Casa.
Adicionalmente, corpo docente qualificado: Professores com ampla experiência acadêmica e profissional.
Também, atuação prática: Vivência clínica desde o início do curso.
Por fim, parcerias estratégicas: Integração com serviços de saúde de excelência.
Localização
O campus da FCMSCSP está situado no bairro de Santa Cecília, no coração de São Paulo, o que facilita o acesso dos alunos e, consequentemente, proporciona uma rica experiência urbana.
Curso de Nutrição da FCMSCSP
Optar pelo curso de Nutrição da FCMSCSP significa investir em uma formação sólida, prática e reconhecida nacionalmente. Assim, você se prepara para ser um profissional capaz de transformar vidas por meio da alimentação e da saúde.
Posts recentes
-
 Fisioterapia esportiva dá dinheiro? Veja salários e mercadojunho 26, 2026
Fisioterapia esportiva dá dinheiro? Veja salários e mercadojunho 26, 2026 -
 Vale a pena fazer pós em fisioterapia cardiorrespiratória?junho 23, 2026
Vale a pena fazer pós em fisioterapia cardiorrespiratória?junho 23, 2026 -

-

-

-
 Pós-Graduação em Enfermagem Cardiovascular: vale a pena?junho 9, 2026
Pós-Graduação em Enfermagem Cardiovascular: vale a pena?junho 9, 2026
Conheça os Nossos Cursos
Desenvolvido por Consultoria Digital